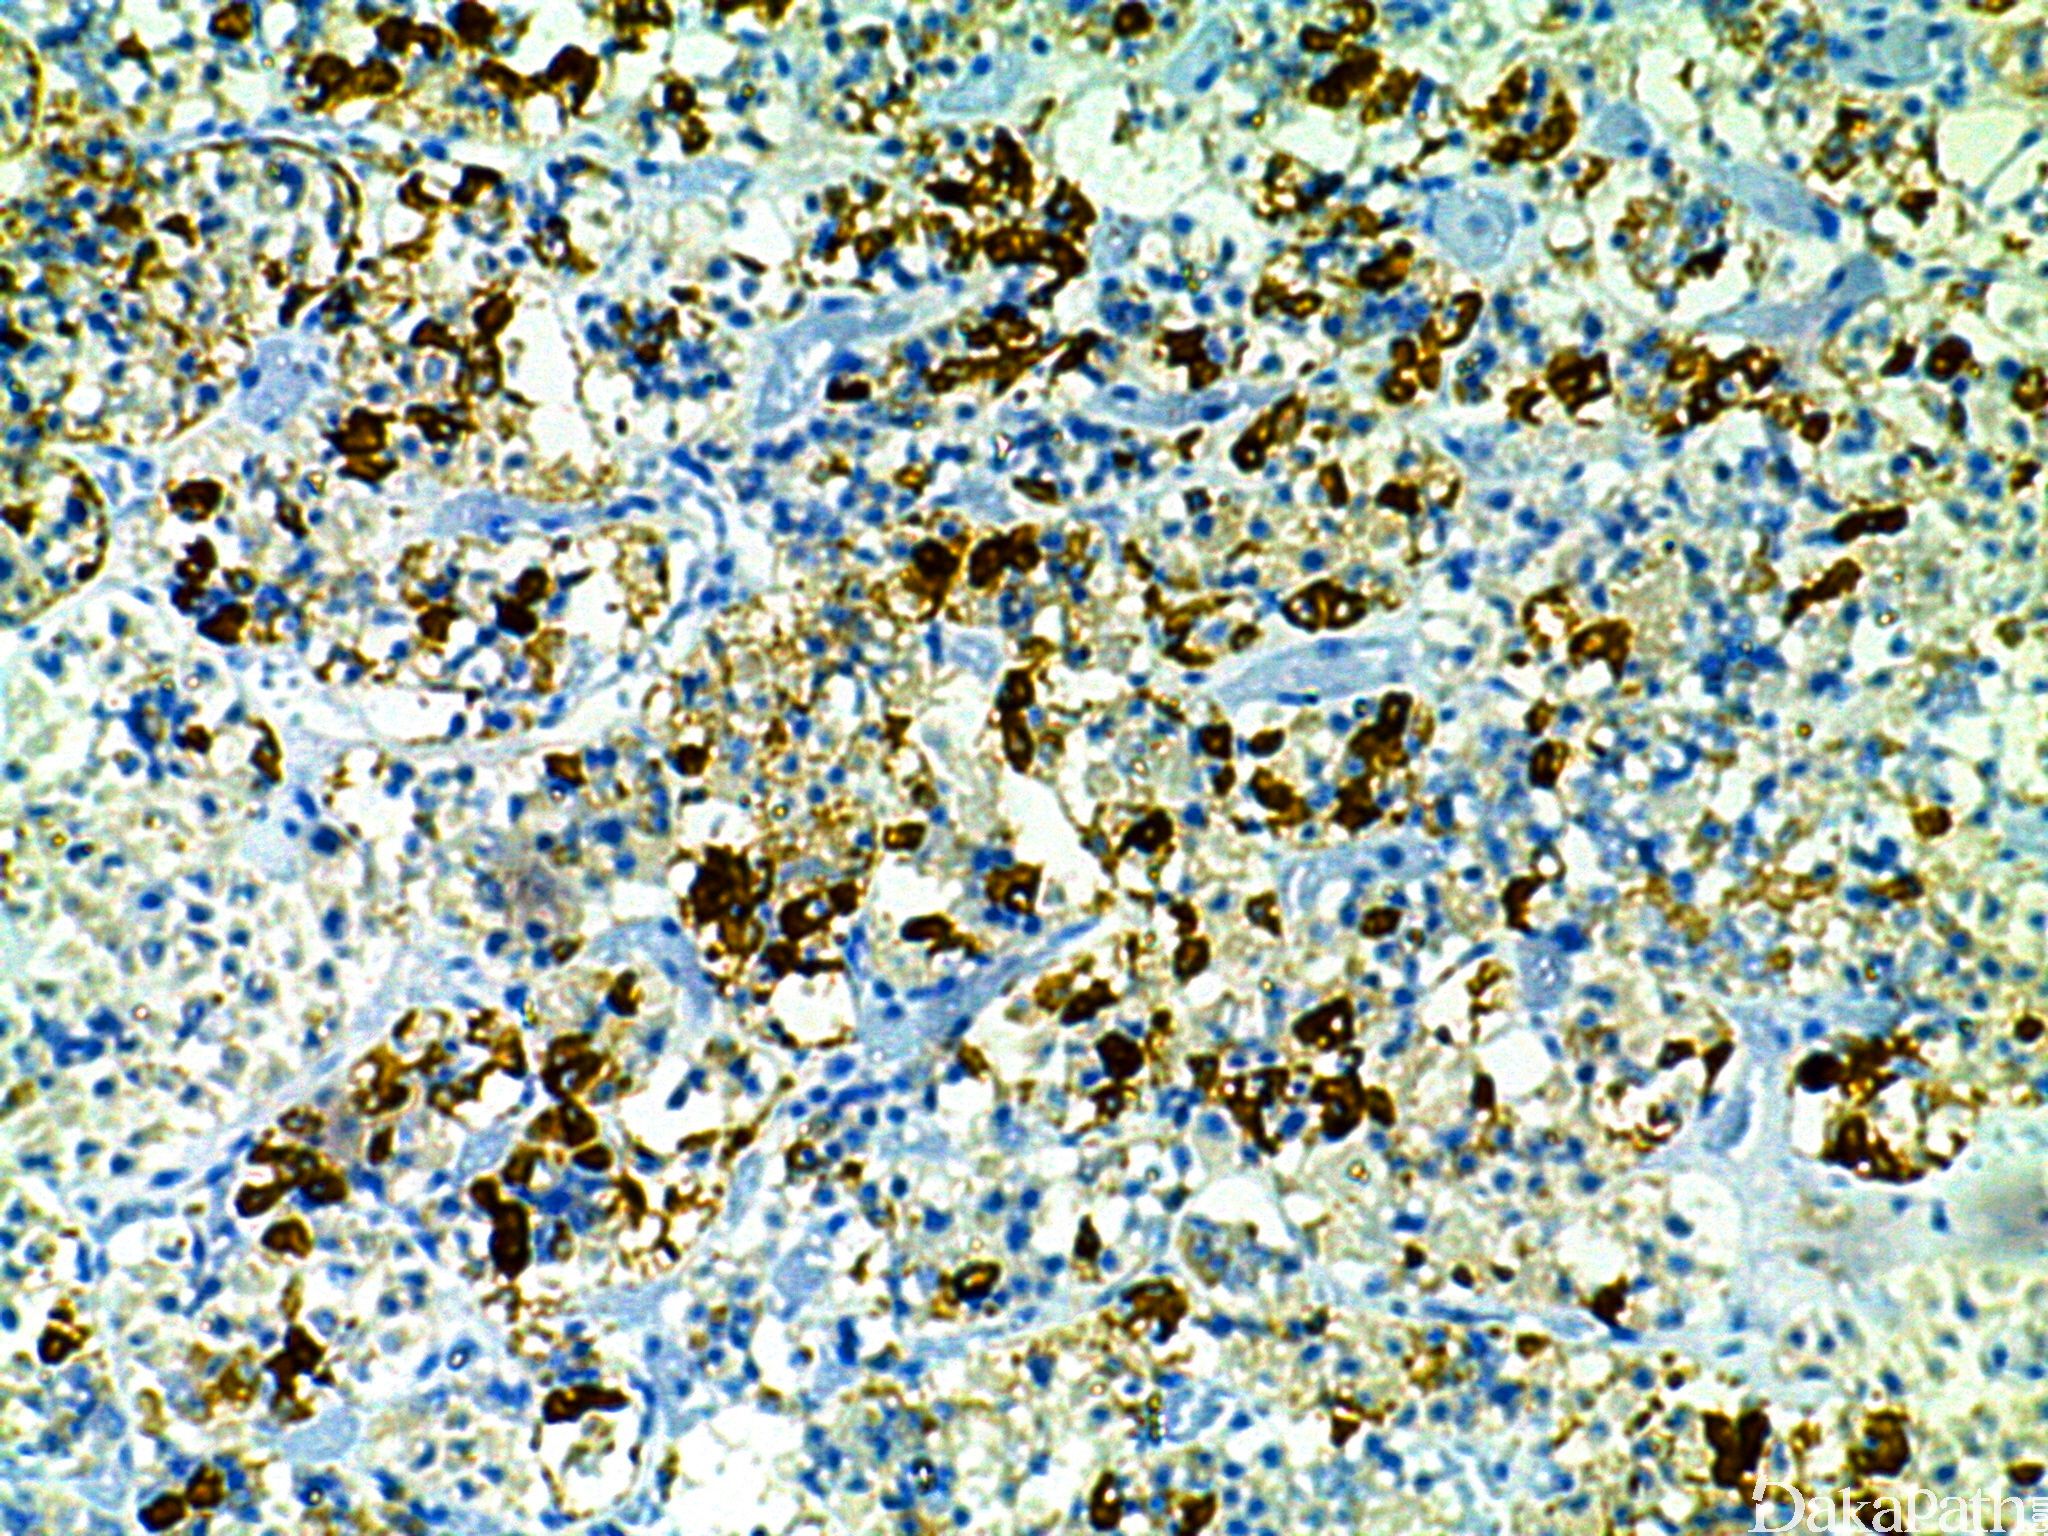

TSH
别名: Thyroid stimulating hormone;thyrotropin。
概述:
促甲状腺激素,甲状腺刺激素,由脑垂体甲状腺刺激素细胞分泌。
信号定位: 胞质
在病理学中的应用:
- 垂体腺瘤功级分型;
- 原发性垂体腺瘤与转移癌的鉴别。
商品化试剂(排名不分先后,本网站对抗体质量不负责!)
公司 | 克隆号 | 即用型(ml) | 原液(ml) | ||||
基因科技 | TSH01+TSH02 | / | 2 | 4 | 7 | / | 0.2 |
中杉金桥 | TSH01+TSH02 | 1.5 | 3 | 6 | / | 0.1 | 0.2 |
EP254 | |||||||
安必平 | / | 1.5 | 3 | 6 | / | 0.1 | 0.2 |
在肿瘤中的表达情况:
几乎全部阳性(≥95%的病例阳性): 垂体腺瘤,分泌促甲状腺激素
几乎全部阴性(<5%的病例阳性): 垂体腺瘤,裸细胞、脑垂体梭形细胞嗜酸细胞瘤